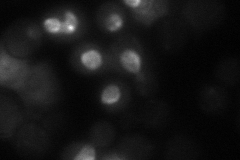
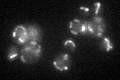

View description
Essential nuclear protein, constituent of 66S pre-ribosomal particles; required for maturation of 25S and 5.8S rRNAs; required for maintenance of M1 satellite double-stranded RNA of the L-A virus
Localization:
Intensity:
Fold change:
Significance:
-
C’ GFP library in SD

mitochondria35.7 -
N' NOP1pr-GFP in SD

punctate,nucleus126.102 -
N' TEF2pr-mCherry in SD

missing0 -
N' NATIVEpr-GFP in SD
punctate,nucleolus18.0822 -
N' TEF2pr-VC and Cyto-VN in SD

nucleus,nucleolus41.8846 -
C’ GFP library in SD+DTT

mitochondria34.910.97No -
C’ GFP library in SD+H2O2

mitochondria39.511.1No -
C’ GFP library in Starvation Media
mitochondria41.941.17No -
C’ GFP library on the background of Pup2-DaMP

mitochondria -
C’ GFP library on the background of CCT mutant

mitochondriaN/AN/ANo
